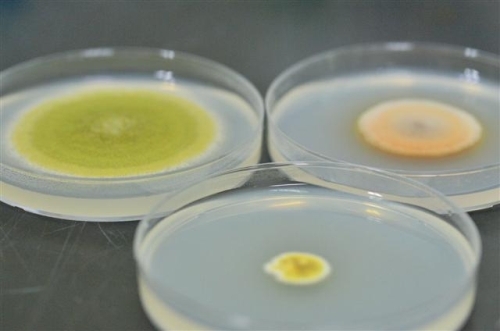

고부가 식품 기술 개발 선정 / 국비확보 10억 5000만원 / 장류 기능적 차별화 박차
군에 따르면 이번 연구는 지역농식품 선도 클러스터 선행 연구과제 성과를 활용해 기획됐으며 전북대학교 RRC(지역혁신연구센터), 원광대학교 대사성질환연구소, 순창군 발효미생물관리센터, (농)순창장류 주식회사가 참여하는 과제로 사업비는 3년간 국비 10억5000만원 등 총 15억9000만원이 투입된다.
그동안 국가차원에서 전략적으로 상당한 미생물 자원을 확보했으나, 제대로 된 산업화 정보 부족으로 기업체에서 활용치 못하고 있는 실정이었다.
또한 2010년 일본 나고야에서 유전자원 접근 및 이익공유(ABS) 의정서가 채택되어 2014년에 발효될 예정으로 수입균주의 산업화시 원 소유 국가의 사전 동의가 필요하고, 자원 개발이익을 해당국가와 공유함으로써 국부 유출이 우려되고 있다.
군에 따르면 특히 장류 및 막걸리, 유산균 발효음료 균주의 대부분이 외국 특허 균주로 상당한 피해가 예상되어 이에 따른 바이오 산업의 피해액도 5000천억 정도에 이르는 것으로 조사되고 있다.
군 관계자는“순창을 대표하는 고초균과 유산균, 효모, 곰팡이의 자원화가 무엇보다 시급한 실정”이라며 “향후 순창장류의 대외적 기능적 차별화를 위해서도 순창장류에 맞는 특별한 기능성(항당뇨, 항고혈압, 항비만, 항고지혈증 등)을 가진 토착발효미생물을 확보할 계획”이라고 밝혔다.
저작권자 © 전북일보 인터넷신문 무단전재 및 재배포 금지
개의 댓글
※ 아래 경우에는 고지 없이 삭제하겠습니다.
·음란 및 청소년 유해 정보 ·개인정보 ·명예훼손 소지가 있는 댓글 ·같은(또는 일부만 다르게 쓴) 글 2회 이상의 댓글 · 차별(비하)하는 단어를 사용하거나 내용의 댓글 ·기타 관련 법률 및 법령에 어긋나는 댓글






